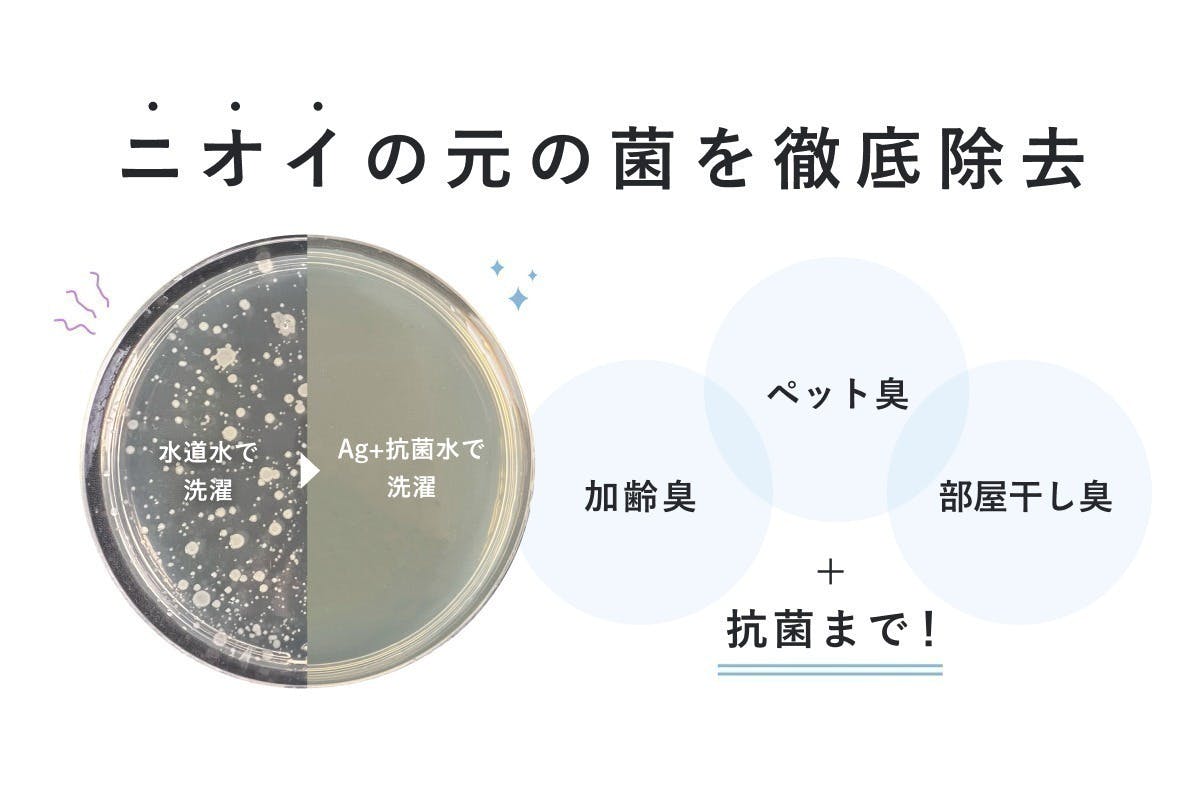
3番目のメイン画像

投稿するには ログイン が必要です。
プロジェクトオーナーの承認後に掲載されます。承認された内容を削除することはできません。





現在の支援総額
18,842,356円
目標金額は20,000,000円
支援者数
2,772人
募集終了まで残り
終了
このプロジェクトは、2024/09/14に募集を開始し、 2,772人の支援により 18,842,356円の資金を集め、 2024/10/31に募集を終了しました

現在の支援総額
18,842,356円
94%達成
目標金額20,000,000円
支援者数2,772人
このプロジェクトは、2024/09/14に募集を開始し、 2,772人の支援により 18,842,356円の資金を集め、 2024/10/31に募集を終了しました
他の方へのコメント回答で、『1回の洗濯水量が約100-150Lの場合目安2ヵ月交換を推奨しております。』とは毎日100-150L使い続けた場合でしょうか?
購入したのですが、いつ届くのでしょうか?
井戸水を使用していますが、フィルターは必要ですか?また、井戸水でも使用ができますか?
洗剤は必要なし!とのことですが、洗濯用洗剤を入れず洗濯しても汚れも落ち、不要になるということですか?
使用するには本体・アダプター・ケース・活性炭フィルターの4点が必要ですか? 交換するのは活性炭フィルターのみですか?
フィルターの交換頻度がわからない
活性炭フィルターの取替は、洗濯何回とか水量何リットルか教えてください。 フィルターのオプションも購入するか検討したいので。